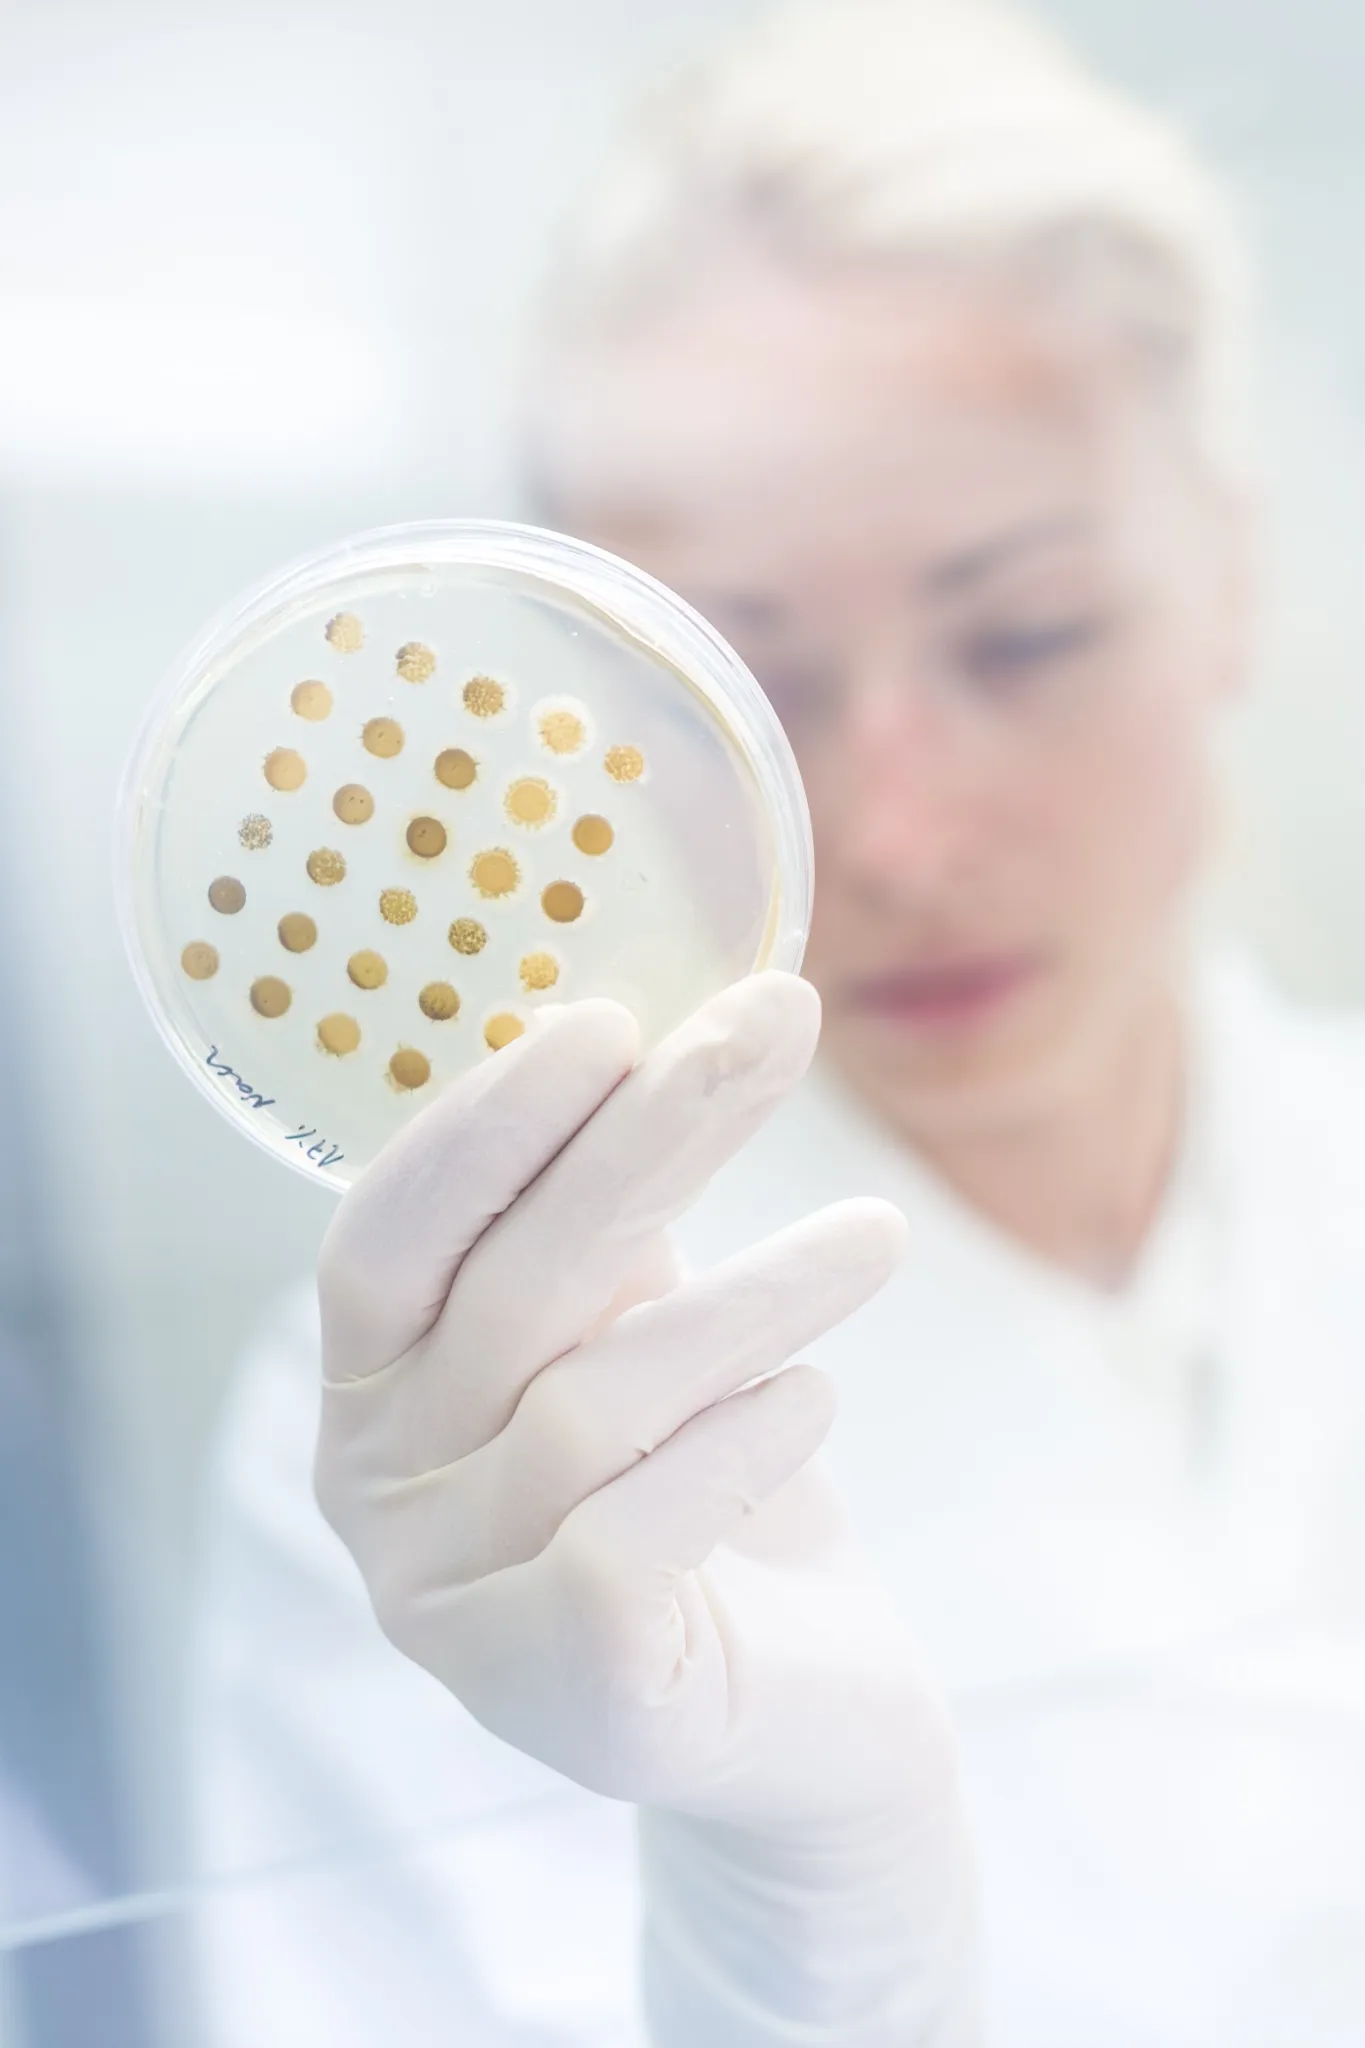

Añade aquí tu texto de cabecera
Lorem ipsum dolor sit amet, consectetur adipiscing elit. Ut elit tellus, luctus nec ullamcorper mattis, pulvinar dapibus leo.
Añade aquí tu texto de cabecera
Lorem ipsum dolor sit amet, consectetur adipiscing elit. Ut elit tellus, luctus nec ullamcorper mattis, pulvinar dapibus leo.
Añade aquí tu texto de cabecera
Lorem ipsum dolor sit amet, consectetur adipiscing elit. Ut elit tellus, luctus nec ullamcorper mattis, pulvinar dapibus leo.
Añade aquí tu texto de cabecera
Lorem ipsum dolor sit amet, consectetur adipiscing elit. Ut elit tellus, luctus nec ullamcorper mattis, pulvinar dapibus leo.




Our signature wellness services
Nurturing your mind, body, and spirit
Tratamiento acné
Regula la piel grasa, reduce brotes e imperfecciones, dejando el rostro más limpio y uniforme.

Tratamiento manchas
Unifica el tono, aclara hiperpigmentaciones y devuelve luminosidad al rostro.

Tratamiento antiaging
Combina activos avanzados para frenar el envejecimiento y mantener una piel joven.

Tratamiento reafirmante
Reestructura la piel flácida, devolviendo firmeza y elasticidad.

Tratamiento anti arrugas
Suaviza líneas de expresión y arrugas, estimulando el colágeno para una piel más joven.

Tratamiento bolsas/ojeras
Reduce la hinchazón y atenúa el color oscuro, devolviendo frescura y descanso a la mirada.

Tratamiento vitamida c
Potente antioxidante que ilumina, revitaliza y protege la piel contra el envejecimiento.

Tratamiento celulas madre
Regenera y rejuvenece la piel desde dentro, mejorando firmeza y vitalidad.
Dermapén
Microperforaciones que estimulan colágeno y elastina, mejorando arrugas, cicatrices y textura

Tratamiento peeling químico
Exfoliación profunda que renueva la piel, ideal para manchas, acné y envejecimiento.

Tratamiento de peptidos
Nutre y activa las células de la piel, mejorando firmeza y suavidad.

Tratamiento de exoxomas
Innovación biotecnológica que regenera y rejuvenece, con resultados visibles en luminosidad y elasticidad.

Cosmelan
Tratamiento médico-estético líder en despigmentación que elimina manchas y mejora la uniformidad del rostro.





¿Te interesA alguno de nuestros masajes?
Rellena el cuestionario a continuación y te contactaremos a la mayor brevedad para resolver todas tus dudas, informarte de precios y conocer tu disponibilidad para agendar un cita.

¿QUIERES CONOCER OTROS SERVICIOS?
No solo hacemos masajes ni mucho menos, pincha en el siguiente botón para conocer todos los servicios que ofrecemos en cuatro estaciones belleza.
¿Quieres conocer todos nuestros servicios?
No solo hacemos masajes ni mucho menos, pincha en el siguiente botón para conocer todos los servicios que ofrecemos en cuatro estaciones belleza.
